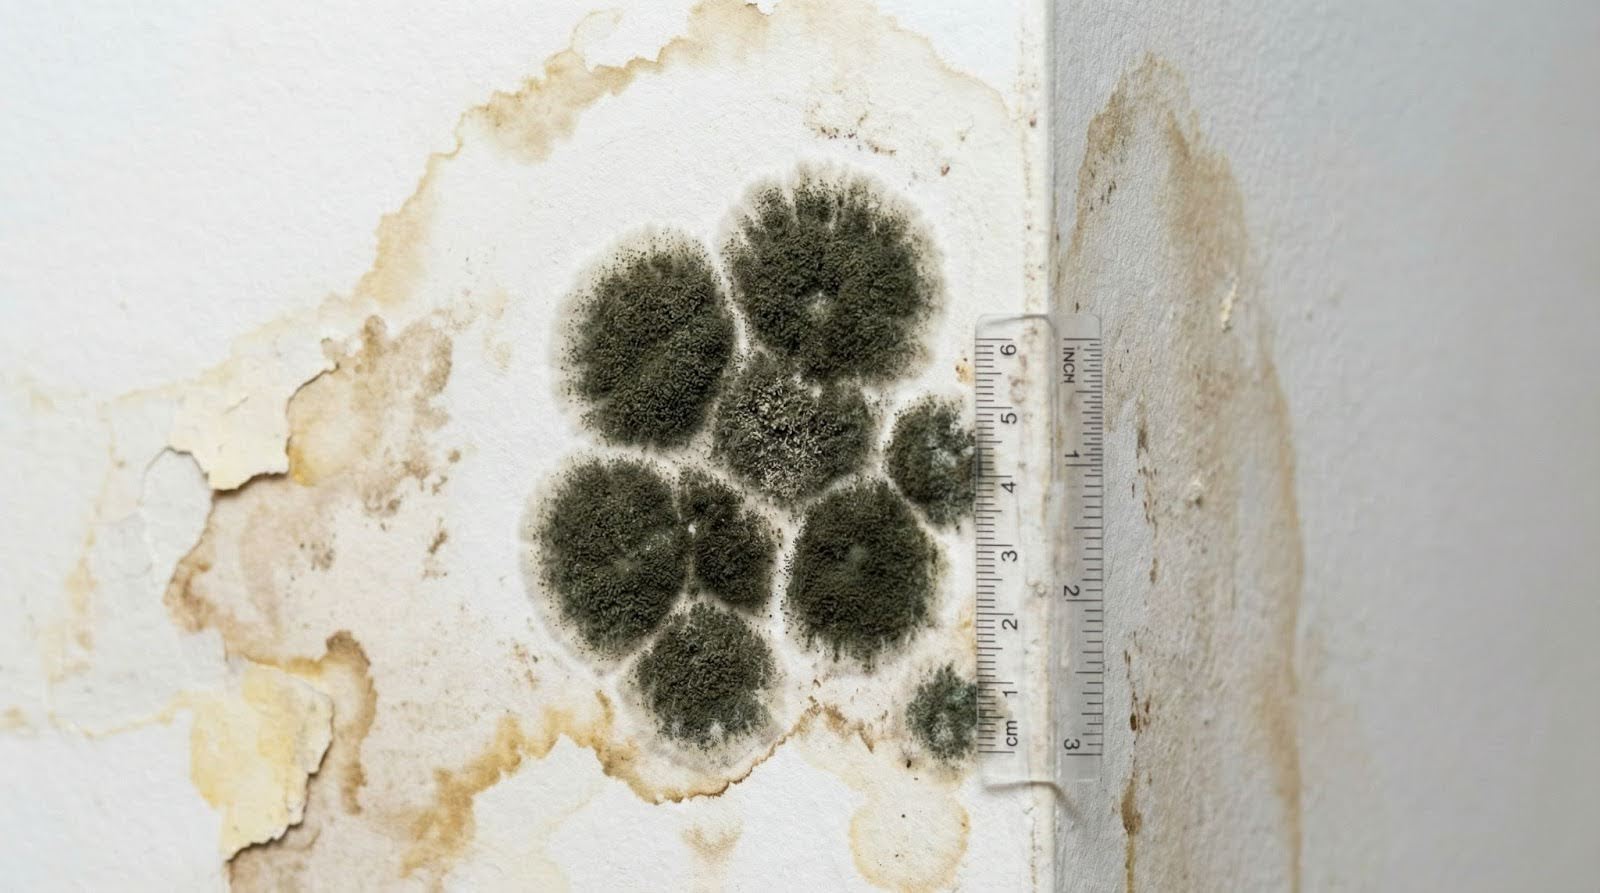

Mold exposure while pregnant is a real concern for anyone trying to protect a developing baby and maintain a healthy home environment. Indoor mold exposure can affect breathing, trigger allergic reactions, and may contribute to certain pregnancy complications when mold problems are not addressed.
Mold Exposure During Pregnancy and Health Risks
Mold exposure during pregnancy usually happens when mold spores from indoor mold are inhaled, touched, or occasionally ingested in dust. These spores can irritate the airways, eyes, and skin and may trigger allergic reactions and asthma symptoms in pregnant women, particularly those who already have allergies or respiratory issues.
Studies of pregnancy exposure to damp and moldy housing have linked long‑term exposure to an increased risk of low birth weight and other adverse outcomes, although not every mold exposure will affect pregnancy in the same way. Because pregnancy naturally alters the immune system, a pregnant person may be more sensitive to exposure to mold and may notice health issues such as fatigue, headaches, sinus problems, or respiratory issues that seem worse at home. Learn more about the effects of black mold and symptoms of toxic mold exposure.
Black Mold Exposure and Stachybotrys Toxins
Black mold, especially greenish black mold known as Stachybotrys chartarum, can be found in humid environments and on materials that stay wet, such as drywall, paper, or ceiling tiles after water damage. Black mold exposure may involve breathing in spores or stachybotrys toxins, which are mold toxins that can irritate the lungs, skin, and eyes and may contribute to more serious health risks with high exposure over time.
Animal studies in pregnant mice and other models show that some mycotoxins can cross the placenta and affect fetal development, although low doses in everyday homes may not have the same effect as large quantities used in research. Human research suggests that prenatal exposure to certain mycotoxins is associated with low birth weight and other outcomes in babies, but birth defects are not clearly linked to typical household mold exposure. Still, any visible mold, especially black mold growth, is a reason to take action and evaluate hidden areas for a larger mold problem.
How Mold Can Affect Pregnancy, Fetal Development, and Baby’s Health
Maternal mycotoxin exposure and long‑term indoor mold exposure have been associated with increased risk of low birth weight, preterm birth, and respiratory problems in infants, even when the exact role of mold toxins is still being clarified by scientific studies. These health risks appear higher in homes with chronic dampness, strong moldy odors, or extensive mold growth that is not addressed.
Mold exposure during pregnancy does not seem to directly cause structural birth defects in most studies, but it may affect pregnancy by influencing placental function, the immune system, and inflammation, which can indirectly impact the developing fetus and baby’s health. Because a weakened immune system and underlying asthma can make people sick more easily, pregnant women and expecting mothers who already have asthma or allergies may notice that exposure to mold increases symptoms such as wheezing, chest tightness, or persistent cough.
Allergic Reactions, Allergic Responses, and Symptoms
Indoor mold can trigger allergic reactions and allergic responses, especially in pregnant people who are sensitized to mold spores. Common symptoms include sneezing, runny or stuffy nose, eye irritation, skin rashes, coughing, and shortness of breath, and asthma symptoms may worsen with ongoing exposure to mold.
Health problems related to exposure to mold can also include headaches, fatigue, and sinus infections, particularly those that seem to improve when away from the home. Because harsh chemicals and some household cleaners can further irritate the lungs and skin, a pregnant person with allergies or asthma should avoid strong fumes and instead use milder cleaning options, such as water and baking soda, for small spots on hard, non‑porous surfaces.
Indoor Mold, Mold Growth, and Moisture

Indoor mold growth is closely tied to moisture levels, humid environments, and water damage. Mold can grow in humid areas like bathrooms with poor ventilation, around bathroom tiles, basements, laundry rooms, near air conditioner units, and in hidden areas behind walls or under flooring where leaks have occurred. Professional indoor air quality testing can help identify hidden mold problems and assess the overall air quality in your home.
Visible mold, especially when combined with a musty odor, often means there may be more mold growth in hidden areas that are not obvious at first glance. If mold increase is noticed after a leak, flood, or condensation problem, it is worth noting that materials such as drywall, insulation, and carpet can hold moisture and support mold during pregnancy and beyond if not dried and cleaned properly.
Prevent Mold Growth and Disease Control Steps

To prevent mold growth and reduce health risks, disease control guidance from public health agencies focuses on moisture control, ventilation, and safe cleanup practices. Important steps include:
- Control moisture levels. Keep indoor humidity below about 50
percent using dehumidifiers or air conditioner systems and repair roof, plumbing, or window leaks promptly to prevent water damage. - Use exhaust fans. Run exhaust fans in bathrooms, kitchens, and
laundry rooms to vent moisture outside, and improve airflow in closets and other tight spaces where humid air can collect. - Dry wet materials quickly. Dry carpets, furniture, and building
materials within 24 to 48 hours after any spill or flood so mold spores do not have time to colonize and grow. - Avoid painting over mold. Do not cover visible mold with paint
or caulk, because mold will continue to grow behind the surface and can still affect pregnancy and overall health.
Pregnant women and pregnant people should not take on large mold cleanup projects themselves, especially when there is high exposure or extensive damage. For bigger projects, professional mold killing products and methods used by trained remediators are safer than home attempts, since they combine proper ventilation, containment, and protective equipment.
Safe Cleanup: Protective Gear and What to Avoid
For small areas of mold on hard, non‑porous surfaces, a non‑pregnant household member may sometimes clean using detergent, water, and gentle scrubbing while wearing non porous gloves and basic eye protection to avoid direct contact with mold and cleaning agents. Professional surface sampling can help identify the type and extent of mold contamination before cleanup begins. Even in these cases, the pregnant person should stay out of the room until the area is thoroughly cleaned and dried and the space is well ventilated.
In situations with large quantities of mold, widespread water damage, or black mold exposure, professional remediation is recommended because these scenarios can release high levels of spores and mold toxins. Harsh chemicals such as strong bleach solutions, mixed household cleaners, or industrial products should be avoided by pregnant women due to the fumes and potential respiratory irritation they can cause.
When To Call a Healthcare Provider
A healthcare provider should be consulted if exposure to mold is followed by persistent or severe symptoms such as significant breathing difficulty, chest tightness, ongoing cough, skin rashes that do not resolve, or systemic symptoms like fever or extreme fatigue. This is particularly important for pregnant women, those with asthma, allergies, or a weakened immune system, and babies or young children in the home.
Teratology information specialists and clinical resources like MotherToBaby emphasize that while mold during pregnancy has not been clearly proven to cause birth defects in humans, ongoing exposure in damp, moldy environments may affect pregnancy outcomes, and reducing exposure is a sensible precaution. If there are concerns that mold might affect pregnancy, fetal development, or the developing fetus, a healthcare provider can help evaluate risks and recommend environmental changes or further testing.
Professional Mold Inspection for Expecting Mothers

Because exposure to mold can be stressful and confusing, especially for expecting mothers, a professional mold inspection provides clarity about the extent of indoor mold exposure and the steps needed to improve conditions. Certified inspectors can locate hidden mold problems, measure moisture levels, and identify humid areas or hidden areas where leaks and mold growth are likely.
SafeAir Certified Mold Inspection Inc. uses advanced tools and science‑based methods to find black mold, other mold species, and moisture sources without unnecessary demolition. This approach helps protect pregnant women, babies, and families by guiding safe remediation and minimizing additional exposure during the cleanup process. After remediation is complete, post-remediation clearance testing ensures that mold levels have returned to safe levels before families reoccupy treated areas.
Conclusion and Next Steps

Mold exposure during pregnancy is worth taking seriously, even at low doses, because chronic dampness and mold can affect pregnancy outcomes, respiratory health, and comfort in the home. While more research is needed to fully understand how different mold toxins affect pregnancy and babies, it is clear that reducing exposure to mold, correcting water damage quickly, and improving ventilation are important steps for protecting maternal and fetal health.
If you are an expecting mother or pregnant person who is worried about exposure to mold, visible mold growth, or persistent musty odors in your home, professional help can make a real difference. Serving families throughout North Carolina and Georgia, contact SafeAir Certified Mold Inspection Inc. for comprehensive mold testing and inspection that focuses on health risks for pregnant women, developing babies, and families.
Protect your home and your baby’s health. Visit SafeAir Certified Mold Inspection Inc. or call 404‑695‑3610 to schedule your mold inspection today.




